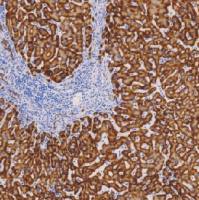
鼠抗人HBsAg单克隆抗体  TDCHM-0121

相关产品推荐更多 >
万千商家帮你免费找货
0 人在求购买到急需产品
- 详细信息
- 文献和实验
- 技术资料
- 形态:
Liquit
- 保存条件:
-20℃
- 克隆性:
单克隆
- 适应物种:
Human,(predicted:Mouse,Rat,)
- 保质期:
1年
- 抗原来源:
peptiede
- 目录编号:
TDCEM-0010
- 级别:
科研级
- 库存:
88
- 供应商:
武汉天德
- 宿主:
鼠
- 浓度:
1mg/ml
- 抗体英文名:
Epstein-Barr virus(LMP-1)
- 抗体名:
Epstein-Barr virus(LMP-1)
- 规格:
1ml工作液

Epstein-Barr virus(LMP-1)(EBV)鼠抗人EB病毒单克隆抗体
EB病毒是8种已知的人疹病毒之一,属于v疯疹病毒亚科,与人疤疹病毒8型(HHV-8)属于同一亚家族。疹病毒具有大双链DNA基因组,为复合病毒,通常编码超过35种蛋白,除病毒结构蛋白外,包括涉及核酸代谢、DNA合成与蛋白加工的酶。这些病毒在宿主体内潜伏期无明显的感染症状,并且传染原水平非常低。在潜伏期,病毒基因表达仅限于少量基因。潜伏期膜蛋白(LMP-1)为EB病毒BNLF1基因编码的60kD蛋白
- 货号:TDCEM-0010
- 克隆号:CS1/CS2 /CS3 /CS4混合物
- 阳性部位:胞质
- 适用组织:石蜡切片
- 预处理:热修复
风险提示:丁香通仅作为第三方平台,为商家信息发布提供平台空间。用户咨询产品时请注意保护个人信息及财产安全,合理判断,谨慎选购商品,商家和用户对交易行为负责。对于医疗器械类产品,请先查证核实企业经营资质和医疗器械产品注册证情况。
文献和实验以单克隆抗体为基础的免疫治疗 第1代单抗诞生于1975年,来源于小鼠的B细胞杂交瘤,称为鼠源单抗。但人的免疫系统会识针对此类识别单抗产生人抗鼠抗体,将其清除出体外而限制了它的应用。随后研制了人源化单抗,并于1988年进行了第1次商业性的临床试验。人源化单抗与鼠源单抗相比,具有以下的优点:特异性较强;不易发生过敏反应及免疫复合性疾病;在人体内维持的时间较长;可制备用于人的抗独特型抗体。制备人源化单抗可以采用人―鼠杂交瘤技术、人―人杂交瘤技术、EB病毒转化技术、EB病毒转化
抗体/补体介导的特异性细胞毒作用分离法分离T细胞亚群 人T淋巴细胞按其表面标志分为CD4+ T和CD8+ T细胞两类,其细胞膜上分别有CD4和CD8分子,当它们与相应的鼠抗人单克隆抗体结合后,在补体的参与下,可溶解相应的T细胞亚群,从而分离出另一种细胞亚群。 【试剂及配制】 (1) 聚蔗糖-泛影葡胺分层液(D=1.077±0.001)。 (2) Hank’s液(内含5%小牛血清和1.0g/L叠氮钠)。
R&D Systems 适用于神经细胞培养的无血清培养基添加剂
。 海马神经元表现出突触标记的可靠表达。e18大鼠海马神经元用添加了N21-MaX Media Supplement(目录号ar008)的培养基在体外培养21天。(a) 利用小鼠抗大鼠突触结合蛋白-1单克隆抗体(目录号MaB4364),以及Northernlights™ 557结合的驴抗小鼠igg二抗(目录号Nl007;黄色)对细胞染色,或(B) 利用小鼠抗人caM激酶iiα单克隆抗体(目录号MaB5584),接着用Northernlights™ 557结合的驴抗小鼠 igg二抗(目录号Nl
技术资料暂无技术资料 索取技术资料